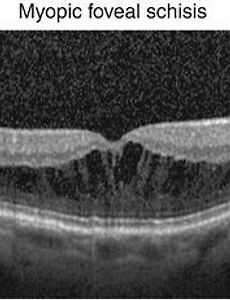

병적 고도근시와 후포도종(posterior staphyloma), 중심와 분리증(myopic foveoschisis), 근시성 황반원공(myopic macular hole)
눈의 도수로는 -6 디옵터의 굴절력, 안구의 길이로는 26 mm 의 안축장을 넘는 심한 고도근시에서, 시력 장애를 유발할수 있는 이차적인 안저 변화가 동반된 경우를 병적인 고도근시 (pathologic high myopia)라고 합니다. 이러한 병적 고도근시는, 성장과정에서 발생한 일반적인 고도근시와는 달리, 눈의 도수는 점점 나빠지고, 안축장의 길이 역시 점점 나빠지는것이 특징입니다. 이러한 병적 고도근시에서 가장 중요한 소견은, 안구에서 가장 질긴 조직이자, 안구의 형태를 유지해주는 가장 중요한 조직인 공막(sclera)조직이 늘어나고, 약해지는 것입니다. 이를 안구조직이 포도송이 처럼 늘어난다고 하여, 안구 포도종 (staphyloma)이라고 하며, 특히 안구의 뒤편이 늘어나기 때문에, 이를 안구 ..
2018. 6. 24.
병적 고도근시와 후포도종(posterior staphyloma), 중심와 분리증(myopic foveoschisis), 근시성 황반원공(myopic macular hole)
눈의 도수로는 -6 디옵터의 굴절력, 안구의 길이로는 26 mm 의 안축장을 넘는 심한 고도근시에서, 시력 장애를 유발할수 있는 이차적인 안저 변화가 동반된 경우를 병적인 고도근시 (pathologic high myopia)라고 합니다. 이러한 병적 고도근시는, 성장과정에서 발생한 일반적인 고도근시와는 달리, 눈의 도수는 점점 나빠지고, 안축장의 길이 역시 점점 나빠지는것이 특징입니다. 이러한 병적 고도근시에서 가장 중요한 소견은, 안구에서 가장 질긴 조직이자, 안구의 형태를 유지해주는 가장 중요한 조직인 공막(sclera)조직이 늘어나고, 약해지는 것입니다. 이를 안구조직이 포도송이 처럼 늘어난다고 하여, 안구 포도종 (staphyloma)이라고 하며, 특히 안구의 뒤편이 늘어나기 때문에, 이를 안구 ..
2018. 6. 24.
 변성근시에서의 근시 코누스(myopic conus)와 망막색소상피(RPE) 및 맥락막의 얇아짐
앞선 포스팅을 통해, 병적인 고도근시, 변성근시(병적근시)의 정의, 원리, 발생 기전에 대해서 알아보았습니다. [안과 질환과 안과 치료/망막] 병적근시 (pathologic myopia), 변성근시(degenerative myopia), 퇴행성변화를 보이는 고도근시 이번에는, 변성근시에서 관찰되는 대표적인 안저 소견인, 근시 코누스(myopic conus), 망막 및 맥락막의 얇아짐에 대해서 알아보겠습니다. 코누스(conus)란.. 원추, 깔대기, 마개라는 독일어인 Konus 에서 유래된 단어로, 각막이 깔대기처럼 변하는 각막 변성 질환을 원추각막(keratoconus)이라고 표현하며, 시신경 유두의 모양이 깔대기 처럼 변하는, 변성근시의 시신경 소견을 근시 코누스(myopic conus)라고 표현합니다..
2018. 6. 23.
변성근시에서의 근시 코누스(myopic conus)와 망막색소상피(RPE) 및 맥락막의 얇아짐
앞선 포스팅을 통해, 병적인 고도근시, 변성근시(병적근시)의 정의, 원리, 발생 기전에 대해서 알아보았습니다. [안과 질환과 안과 치료/망막] 병적근시 (pathologic myopia), 변성근시(degenerative myopia), 퇴행성변화를 보이는 고도근시 이번에는, 변성근시에서 관찰되는 대표적인 안저 소견인, 근시 코누스(myopic conus), 망막 및 맥락막의 얇아짐에 대해서 알아보겠습니다. 코누스(conus)란.. 원추, 깔대기, 마개라는 독일어인 Konus 에서 유래된 단어로, 각막이 깔대기처럼 변하는 각막 변성 질환을 원추각막(keratoconus)이라고 표현하며, 시신경 유두의 모양이 깔대기 처럼 변하는, 변성근시의 시신경 소견을 근시 코누스(myopic conus)라고 표현합니다..
2018. 6. 23.
 병적근시 (pathologic myopia), 변성근시(degenerative myopia), 퇴행성변화를 보이는 고도근시
근시(myopia)란, 가까이 있는 사물은 잘보이고, 멀리있는 사물은 잘 보이지 않는 상태로, 눈에 힘을 주지 않고 (조절이 일어나지 않은 상태) 편안하게 있는 상태에서, 눈에 들어같 빛은 망막보다 앞쪽에 상을 맺게되는 광학적인 상태를 의미합니다. 이때 망막보다 앞쪽에 맺혀지는 상을 망막위에 정확하게 닿게 하기위해서 필요한 것이.. 빛을 퍼뜨려주는 역할을 하는 오목렌즈 입니다. 흔히 안과에서 환자나, 보호자에게, "근시가 있다"는 이야기를 하면, "시력이 마이너스 이냐"는 질문을 받게됩니다. 하지만, 시력에는 마이너스 시력이란 것은 없습니다. 시력은 항상 0 보다 큰 숫자로, 0.1, 0.2, 0.3 등 분수나 소수로 표현하게됩니다. 0.1 이라는 가장 큰 시표 역시 보지 못하는 경우에는, 0.1 * 3..
2018. 6. 22.
병적근시 (pathologic myopia), 변성근시(degenerative myopia), 퇴행성변화를 보이는 고도근시
근시(myopia)란, 가까이 있는 사물은 잘보이고, 멀리있는 사물은 잘 보이지 않는 상태로, 눈에 힘을 주지 않고 (조절이 일어나지 않은 상태) 편안하게 있는 상태에서, 눈에 들어같 빛은 망막보다 앞쪽에 상을 맺게되는 광학적인 상태를 의미합니다. 이때 망막보다 앞쪽에 맺혀지는 상을 망막위에 정확하게 닿게 하기위해서 필요한 것이.. 빛을 퍼뜨려주는 역할을 하는 오목렌즈 입니다. 흔히 안과에서 환자나, 보호자에게, "근시가 있다"는 이야기를 하면, "시력이 마이너스 이냐"는 질문을 받게됩니다. 하지만, 시력에는 마이너스 시력이란 것은 없습니다. 시력은 항상 0 보다 큰 숫자로, 0.1, 0.2, 0.3 등 분수나 소수로 표현하게됩니다. 0.1 이라는 가장 큰 시표 역시 보지 못하는 경우에는, 0.1 * 3..
2018. 6. 22.
 망막혈관종성증식 (Retinal angiomatous proliferation, RAP)의 치료
앞선 포스팅을 통하여, 망막혈관종성증식 (Retinal angiomatous proliferation, RAP)의 검사 소견과 증상에 대해서 알아보았습니다. [안과 질환과 안과 치료/망막] 망막혈관종성증식, Retinal angiomatous proliferation, RAP 의 임상양상, 증상, 검사 소견 망막 혈관종성 증식(Retinal angiomatous proliferation, RAP)이란... 문자그대로 망막에 혈관종양(angioma)이 발생한것과 같이, 혈관증식이 관찰된다는 말인데... 혈관증식이란 섬유혈관증식(fibrovascular proliferation), 즉 신생혈관(retinal NV)을 의미하는데, 이러한 신생혈관이 마치 혈관에 발생한 혈관종양(혈관종, angioma)과 같이 ..
2018. 6. 21.
망막혈관종성증식 (Retinal angiomatous proliferation, RAP)의 치료
앞선 포스팅을 통하여, 망막혈관종성증식 (Retinal angiomatous proliferation, RAP)의 검사 소견과 증상에 대해서 알아보았습니다. [안과 질환과 안과 치료/망막] 망막혈관종성증식, Retinal angiomatous proliferation, RAP 의 임상양상, 증상, 검사 소견 망막 혈관종성 증식(Retinal angiomatous proliferation, RAP)이란... 문자그대로 망막에 혈관종양(angioma)이 발생한것과 같이, 혈관증식이 관찰된다는 말인데... 혈관증식이란 섬유혈관증식(fibrovascular proliferation), 즉 신생혈관(retinal NV)을 의미하는데, 이러한 신생혈관이 마치 혈관에 발생한 혈관종양(혈관종, angioma)과 같이 ..
2018. 6. 21.
 망막혈관종성증식, Retinal angiomatous proliferation, RAP 의 임상양상, 증상, 검사 소견
나이관련 황반변성(Age related Macular Degeneration) 즉, Wet type AMD (neovascular AMD) 가 진행하게되면, 신생혈관(Neovascularization, New vessel, NV)이 발생하는데, 이때 맥락막에서부터 신생혈관이 발생하여, 망막쪽으로 자라난다고 하여, 맥락막신생혈관 (Choroidal NV, CNV)이라고 합니다. 한편, 일부 황반변성의 형태에서는, 신생혈관이 생성되어 자라나는 방향이.. 망막에서부터 발생하여, 망막과 망막, 혹은 망막과 맥락막 으로의 혈관 문합이 발생하는데.. 이러한, 망막-망막 혹은 망막-맥락막 혈관 문합을 특징으로 하는 특이한 형태의 삼출성 나이관련황반변성을 망막혈관종성증식 (Retinal angiomatous proli..
2018. 6. 20.
망막혈관종성증식, Retinal angiomatous proliferation, RAP 의 임상양상, 증상, 검사 소견
나이관련 황반변성(Age related Macular Degeneration) 즉, Wet type AMD (neovascular AMD) 가 진행하게되면, 신생혈관(Neovascularization, New vessel, NV)이 발생하는데, 이때 맥락막에서부터 신생혈관이 발생하여, 망막쪽으로 자라난다고 하여, 맥락막신생혈관 (Choroidal NV, CNV)이라고 합니다. 한편, 일부 황반변성의 형태에서는, 신생혈관이 생성되어 자라나는 방향이.. 망막에서부터 발생하여, 망막과 망막, 혹은 망막과 맥락막 으로의 혈관 문합이 발생하는데.. 이러한, 망막-망막 혹은 망막-맥락막 혈관 문합을 특징으로 하는 특이한 형태의 삼출성 나이관련황반변성을 망막혈관종성증식 (Retinal angiomatous proli..
2018. 6. 20.
 결절성 맥락막 혈관병증, Polypoidal choroidal vasculopathy, PCV 의 검사, 특징, 경과, 예후, 치료
앞선 포스팅에이어서... 결절성 맥락막혈관병증(PCV)의 검사양상, 특징, 경과 및 치료에 대해 알아보도록 하겠습니다. [안과 질환과 안과 치료/망막] - 결절성 맥락막 혈관병증, 폴립 모양 맥락막 혈관병, 혈관종성 맥락망막병증, Polypoidal choroidal vasculopathy, PCV 결절성 맥락막혈관병증(PCV)은, 병명 에서 보듯이, 결절(폴립, polyp) 형태를 띄는 혈관확장이 맥락막에서 발생하는데, 이러한 결절들은, 포도송이 모양으로 가지 끝에 달린 모양으로 분포하는 질환입니다. 결절성 맥락막혈관병증 (Polypoidal choroidal vasculopathy, PCV)은... BVN, branching vascular network 이라는... 방사상으로 가지를 치는 선형 혈관..
2018. 6. 19.
결절성 맥락막 혈관병증, Polypoidal choroidal vasculopathy, PCV 의 검사, 특징, 경과, 예후, 치료
앞선 포스팅에이어서... 결절성 맥락막혈관병증(PCV)의 검사양상, 특징, 경과 및 치료에 대해 알아보도록 하겠습니다. [안과 질환과 안과 치료/망막] - 결절성 맥락막 혈관병증, 폴립 모양 맥락막 혈관병, 혈관종성 맥락망막병증, Polypoidal choroidal vasculopathy, PCV 결절성 맥락막혈관병증(PCV)은, 병명 에서 보듯이, 결절(폴립, polyp) 형태를 띄는 혈관확장이 맥락막에서 발생하는데, 이러한 결절들은, 포도송이 모양으로 가지 끝에 달린 모양으로 분포하는 질환입니다. 결절성 맥락막혈관병증 (Polypoidal choroidal vasculopathy, PCV)은... BVN, branching vascular network 이라는... 방사상으로 가지를 치는 선형 혈관..
2018. 6. 19.
 결절성 맥락막 혈관병증, 폴립 모양 맥락막 혈관병, 혈관종성 맥락망막병증, Polypoidal choroidal vasculopathy, PCV
결절성 맥락막혈관병증이란.. 문자그대로, 맥락막의 혈관이 결절, 폴립, polyp 형태를 띄는 질환으로, Polypoidal choroidal vasculopathy, 약어로는, PCV 과거 용어로는, 혈관종성 맥락망막병증, 현재 용어로는, 결절성 맥락막 혈관병증, 폴립모양 맥락막 혈관병 이렇게 불립니다. 결절성 맥락막혈관병증 (Polypoidal choroidal vasculopathy, PCV)은... 방사상으로 가지를 치는 선형의 혈관(BVN, branching vascular network)과, 그 끝 부위에 확장된 결절(PD, polypoidal dilatation)을 가지는 이상 혈관이 생기는 질환입니다. 결절성 맥락막혈관병증 (PCV)은... 브루크막 하에 섬유혈관 증식이 있어, 나이관련 황..
2018. 6. 18.
결절성 맥락막 혈관병증, 폴립 모양 맥락막 혈관병, 혈관종성 맥락망막병증, Polypoidal choroidal vasculopathy, PCV
결절성 맥락막혈관병증이란.. 문자그대로, 맥락막의 혈관이 결절, 폴립, polyp 형태를 띄는 질환으로, Polypoidal choroidal vasculopathy, 약어로는, PCV 과거 용어로는, 혈관종성 맥락망막병증, 현재 용어로는, 결절성 맥락막 혈관병증, 폴립모양 맥락막 혈관병 이렇게 불립니다. 결절성 맥락막혈관병증 (Polypoidal choroidal vasculopathy, PCV)은... 방사상으로 가지를 치는 선형의 혈관(BVN, branching vascular network)과, 그 끝 부위에 확장된 결절(PD, polypoidal dilatation)을 가지는 이상 혈관이 생기는 질환입니다. 결절성 맥락막혈관병증 (PCV)은... 브루크막 하에 섬유혈관 증식이 있어, 나이관련 황..
2018. 6. 18.
 항체주사, Anti-VEGF 눈속 주사를 통한 삼출성 황반변성, 신생혈관의 치료
앞선 포스팅을 통하여, 일반 레이저 및 특수레이저(PDT 레이저)를 이용한, 습성 황반변성에서의 신생혈관의 치료에 대해서 알아보았습니다. [안과 질환과 안과 치료/망막] - 삼출성 황반변성, 습성 황반변성의 치료, 레이저 및 PDT 광역학 레이저 치료 레이저와 특수레이저는 항체주사가 개발되기 이전에 널리 사용되던 방법으로, 여전히 특정한 상황에서는 적응증이 되곤 합니다. 하지만, 레이저 치료들의 제한적인 적응증, 제한된 치료효과, 비용 등으로 인해, 현재는 "Era of Anti-VEGF" 즉, Anti-VEGF 의 시대라고 불릴정도로 항체주사치료가 대세가 되었습니다. 혈관내피성장인자(vascular endothelial growth factor, VEGF)는...혈관내피세포의 성장하여 신생혈관을 유발혈..
2018. 6. 17.
항체주사, Anti-VEGF 눈속 주사를 통한 삼출성 황반변성, 신생혈관의 치료
앞선 포스팅을 통하여, 일반 레이저 및 특수레이저(PDT 레이저)를 이용한, 습성 황반변성에서의 신생혈관의 치료에 대해서 알아보았습니다. [안과 질환과 안과 치료/망막] - 삼출성 황반변성, 습성 황반변성의 치료, 레이저 및 PDT 광역학 레이저 치료 레이저와 특수레이저는 항체주사가 개발되기 이전에 널리 사용되던 방법으로, 여전히 특정한 상황에서는 적응증이 되곤 합니다. 하지만, 레이저 치료들의 제한적인 적응증, 제한된 치료효과, 비용 등으로 인해, 현재는 "Era of Anti-VEGF" 즉, Anti-VEGF 의 시대라고 불릴정도로 항체주사치료가 대세가 되었습니다. 혈관내피성장인자(vascular endothelial growth factor, VEGF)는...혈관내피세포의 성장하여 신생혈관을 유발혈..
2018. 6. 17.
삼출성 황반변성, 습성 황반변성의 치료, 레이저 및 PDT 광역학 레이저 치료
눈의 신경인 망막에서 빛을 받아들이는 세포는 시세포 입니다. 시세포가 일을하다 보면 찌꺼기, 노폐물들이 생기게 되는데, 노폐물 처리를 담당하는 세포는 망막색소상피(RPE, retinal pigment epithelium)입니다. 나이가 들어 노화가 발생하면, RPE 세포들도 기능이 저하되어 찌꺼기 처리가 원활해 지지 못하게되어, 찌꺼기가 망막하에 쌓이게됩니다. 이 찌꺼기는 드루젠이라 하는데, 지속적으로 축적되고 뭉쳐서 커지기 때문에, 망막의 혈액공급에 장애를 가져오게 되고, 혈액공급을 받지 못하는 허혈에 빠진 망막은, VEGF라는 혈관을 생성하게하는 인자를 만들어냅니다. 이 VEGF (Vascular endothelial growth factor, 혈관내피성장인자)라는 인자는, 맥락막 신생혈관(CNV, ..
2018. 6. 16.
삼출성 황반변성, 습성 황반변성의 치료, 레이저 및 PDT 광역학 레이저 치료
눈의 신경인 망막에서 빛을 받아들이는 세포는 시세포 입니다. 시세포가 일을하다 보면 찌꺼기, 노폐물들이 생기게 되는데, 노폐물 처리를 담당하는 세포는 망막색소상피(RPE, retinal pigment epithelium)입니다. 나이가 들어 노화가 발생하면, RPE 세포들도 기능이 저하되어 찌꺼기 처리가 원활해 지지 못하게되어, 찌꺼기가 망막하에 쌓이게됩니다. 이 찌꺼기는 드루젠이라 하는데, 지속적으로 축적되고 뭉쳐서 커지기 때문에, 망막의 혈액공급에 장애를 가져오게 되고, 혈액공급을 받지 못하는 허혈에 빠진 망막은, VEGF라는 혈관을 생성하게하는 인자를 만들어냅니다. 이 VEGF (Vascular endothelial growth factor, 혈관내피성장인자)라는 인자는, 맥락막 신생혈관(CNV, ..
2018. 6. 16.